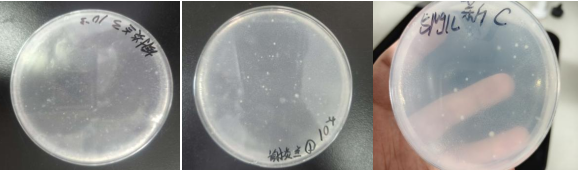

为深化学生对污染物生物降解机制的认知,生命科学与医学技术学院环境科学专业联合教学实验中心,于近日组织开展土壤有机磷农药降解菌筛选教学实验。本次实验紧密结合环境微生物学、环境生态学等核心理论课程内容,进行有机磷农药降解菌筛选的项目式实践教学研究改革。实验以小组合作形式,独立完成了从实验方案汇报、土壤样品处理、菌株筛选、实验结果汇报等全流程操作。实验期间,同学们在老师的指导下每日观察并记录菌落生长情况,特别关注土壤样品中不同菌落的降解能力差异,并从中筛选出降解能力强的菌株,富集培养后验证其降解效果。
学生反映,本次实验不仅提升了土壤微生物分离、筛选及鉴定等基础实验技能,还从科学研究的角度探究了土壤环境中降解菌的分布规律及降解效率。同时,进一步认识有机磷农药污染的环境危害及生物修复技术的应用前景,切实增强环境保护与污染治理的责任担当。

环境科学专业始终秉持理论联系实际的教学原则,以学生为中心,通过开展探究性实验教学,着力提升学生的科学素养与创新能力,为培养高素质环境专业人才提供有力支撑。
通讯员:文少白、张静、陈宏池
一审:符议心
二审:于春伟
三审:李春报